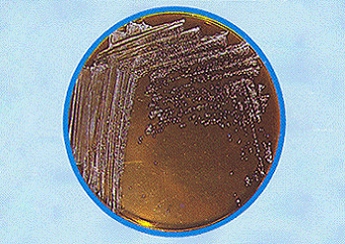

agar zumo de tomate TOMATO JUICE AGAR, medio de cultivo sólido para el recuento de bacterias acidolácticas en productos ácidos
Medio especialmente mejorado por nuestros laboratorios para la detección y recuento rápidos de flora acidoláctica en alimentos, cerveza, vinagres, …
COMPOSICIÓN
- Tween 80 1,00 g
- Extracto de carne 20,00 g
- Extracto de levadura 5,00 g
- Glucosa 20,00 g
- Fosfato dipotásico 2,00 g
- Acetato de sodio 5,00 g
- Citrato triamonio 2,00 g
- Sulfato de Magnesio 0,20 g
- Sulfato de Manganeso 0,05 g
- Agar‑agar 15,00 g
- (Fórmula por litro)
- pH final: 5’5 ± 0,5
PREPARACIÓN
Disolver 70 g en 1 litro de agua destilada que contenga 50 ml del suplemento SDA500 (suero de tomate).
Calentar agitando hasta ebullición. Autoclavar a 121 ºC durante 15 minutos. Evitar el sobrecalentamiento.
PARA USO EXCLUSIVO EN LABORATORIO.
MANTENGA EL BOTE BIEN CERRADO EN LUGAR SECO, FRESCO Y OSCURO. AGITE EL BOTE ANTES DE USAR
DESHIDRATADO CODIGO: DMT079
CONTROL DE CALIDAD DEL MEDIO
Realizado en nuestro laboratorio; es prudente repetirlo en su laboratorio siempre que varíen las condiciones (más de 3 meses sin usar, tras desinfectar laboratorio, tras conservar a alta Tª, cuando adquiere aspectos extraños aunque no haya llegado la fecha de caducidad teórica de la etiqueta,…)
DESHIDRATADO: Polvo grueso, Beige
PREPARADO: Estéril, Ambar opalescente
CONTROL DE CRECIMIENTO 72 h a 37°C aproximadamente, en microaerofilia:
- Lactobacillus plantarum MKTA 8014, Excelente. Con respecto a PCA estandarizado*, recuento >99%.
- Lactobacillus casei MKTA 7830, Excelente.
- Staphylococcus aureus MKTA 6538P, Inhibido.
* El que cumple con recuperación superior al 92-125% con respecto a cepas cuantitativas trazables a la cepa tipo.
PRESENTACIÓN: MEDIO DESHIDRATADO (BASE), FRASCOS PREPARADOS 100 y 250 ml,
MODO DE EMPLEO E INTERPRETACIÓN DE RESULTADOS
Fundir al baño María e inocular en superficie o mejor en profundidad. Incubar a 37 ºC aproximadamente, durante 2-3 días o bien a 30 ºC aproximadamente, durante 3-5 días. Todas las colonias blancas son de Lactobacilos. Este medio da unos resultados mucho más rápidos y exuberantes que otros medios desarrollados para flora acidoláctica.
NOTA: La adición de 0,5 g/l de L- Cisteína (tubos inclinados en pico largo, ref: TPL814) hace el medio más nutritivo y selectivo para Leuconostoc.
El usuario final es el único responsable de la eliminación de los microorganismos según la legislación medioambiental vigente. Autoclavar antes de desechar a la basura.
Si desea más información sobre nuestro TOMATO JUICE AGAR (BASE) (MODIFICADO) rellene nuestro formulario de contacto http://www.medioscultivo.com/contacto . O si lo prefiere póngase en contacto con nosotros a través de nuestro correo electrónico microkit@microkit.es o por teléfono en el nº 91-897 46 16

¿Cuál es el fundamento del Agar de Tomate?
Lo mismo que el agar sangre sirve para microorganismos clínicos, el agar tomate sirve para los microorganismos típicos de los tomates, ya que tiene sus mismos nutrientes